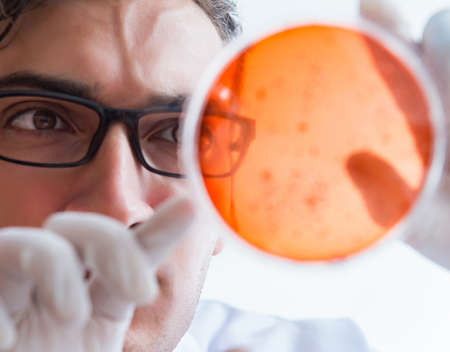

写真素材 - Chemist working in the laboratory with hazardous chemicals
キーワード
- analyzing
- beaker
- biochemistry
- biology
- biotechnology
- capsules
- chemical
- chemist
- chemistry
- clinic
- clinical
- doctor
- drugs
- education
- equipment
- examining
- experiment
- forensic
- glass
- glassware
- health
- healthcare
- hospital
- lab
- laboratory
- man
- medical
- medicine
- medicines
- microbe
- microbiology
- microscope
- pharmaceutical
- pharmacist
- pharmacology
- pharmacy
- pills
- research
- researcher
- sample
- science
- scientific
- scientist
- student
- syringe
- tablets
- technician
- test
- tube
- tubing
類似作品
A row of flasks...
Laboratory with...
A frog in a lab...
Health hazard S...
Close-up of a s...
Close-up of two...
A man stands in...
Scientific equi...
Scientist pipet...
A scientific me...
Chemical glassw...
Pharmacy and ch...
A collection of...
Caution danger ...
Chemistry scien...
Scientist pipet...
background in s...
Virus testing l...
Cartoon Laborat...
Erlenmeyer Flas...
reagents chemis...
Tools and tubes...
chemicals purpl...
Health hazard S...
Glass flasks an...
A close-up of c...
Blood test in t...
Indistinct back...
Laboratory glas...
The blurred abs...
Laboratory glas...
Hand test tube ...
A scientific me...
A row of flasks...
Mysterious doct...
Laboratory flas...
Close-up shows ...
Researchers wor...
Scientist pipet...
Laboratory glas...
Hazardous chemi...
blur image of o...
Laboratory glas...
laboratory chem...
Dusty counterto...
Scientist pipet...
Scientist hand ...
Young male rese...
A futuristic sc...